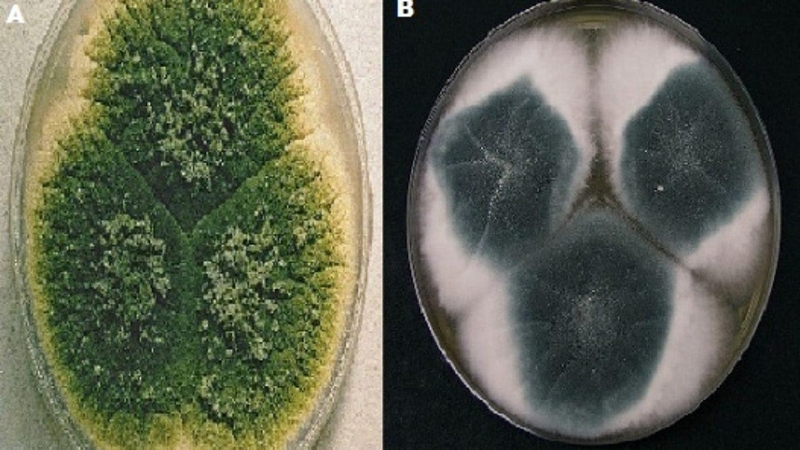
Tìm hiểu về nấm mốc Aspergillus niger 1

Dược sĩ chuyên khoa Dược lý - Dược lâm sàng. Tốt nghiệp 2 trường đại học Mở và Y Dược TP. Hồ Chí Minh. Có kinh nghiệm nghiên cứu về lĩnh vực sức khỏe, đạt được nhiều giải thưởng khoa học. Hiện là Dược sĩ chuyên môn phụ trách xây dựng nội dung và triển khai dự án đào tạo - Hội đồng chuyên môn tại Nhà thuốc Long Châu.
Nấm mốc Aspergillus niger là gì? Một số bệnh lý do Aspergillus niger gây ra
Thảo Hiền
05/05/2024
Mặc định
Lớn hơn
Aspergillus niger là một loại nấm hoại sinh, tức là chúng phát triển trên vật chủ đã chết hoặc vật chủ sống bị yếu đuối. Trong cơ thể con người, nấm mốc Aspergillus niger có thể gây bệnh khi có điều kiện thuận lợi như sử dụng người suy giảm miễn dịch, sử dụng corticoid kéo dài làm rối loạn cân bằng giữa vi khuẩn và nấm hoại sinh.
Có nhiều loại nấm Aspergillus, nhưng trong các trường hợp gây bệnh cho con người, một trong những loài phổ biến nhất thường là Aspergillus niger. Vậy nấm mốc Aspergillus niger là gì và nó có nguy hiểm không? Bài viết dưới đây của Nhà thuốc Long Châu sẽ giải đáp những thắc mắc đó của bạn đọc.
Nấm mốc Aspergillus niger là gì?
Nấm mốc Aspergillus niger, một trong những loài nấm phổ biến, là một phần không thể thiếu của hệ sinh thái tự nhiên và có vai trò quan trọng trong nhiều lĩnh vực khác nhau, từ công nghiệp đến nghiên cứu khoa học và thậm chí trong y học. Với vẻ ngoài phổ biến là một mạng lưới nhỏ của các sợi mốc, Aspergillus niger có thể được tìm thấy ở khắp mọi nơi trong môi trường tự nhiên. Mặc dù tên "niger" gợi lên hình ảnh màu đen, thực tế loài này có thể có màu nâu hoặc xám, phụ thuộc vào điều kiện môi trường.
Tuy nhiên, điều thú vị về Aspergillus niger không chỉ đến từ sự phổ biến của nó trong tự nhiên mà còn từ loạt ứng dụng rộng rãi của nó trong công nghiệp. Trong quá trình sản xuất axit citric, Aspergillus niger được sử dụng như một "nhà máy" để sản xuất axit citric quan trọng, một chất được sử dụng trong nhiều sản phẩm thực phẩm và công nghiệp. Nấm này cũng là nguồn gốc của một số enzyme quan trọng như amylase và protease, có ứng dụng rộng rãi trong ngành công nghiệp thực phẩm và trong quá trình sản xuất các sản phẩm sinh học.
Mặc dù Aspergillus niger thường không gây ra vấn đề sức khỏe đối với người khỏe mạnh, nhưng nó có thể trở thành mối đe dọa cho sức khỏe trong những trường hợp môi trường phát triển phù hợp, cũng như khi hệ miễn dịch của cơ thể suy giảm. Trong điều kiện này, nấm này có thể gây ra các vấn đề sức khỏe như viêm phổi và nhiễm trùng.
Ngoài ra, Aspergillus niger còn có vai trò quan trọng trong nghiên cứu khoa học. Với khả năng phát triển nhanh chóng và độ phổ biến rộng rãi, nó thường được sử dụng như một vi sinh vật mô hình để nghiên cứu các quá trình sinh học và di truyền.
Nấm mốc Aspergillus niger có nguy hiểm không?
Aspergillus niger không thường gây ra nguy hiểm đối với người khỏe mạnh. Tuy nhiên, trong một số trường hợp, nấm này có thể trở thành mối đe dọa cho sức khỏe, đặc biệt là đối với những người có hệ miễn dịch suy giảm hoặc mắc các vấn đề sức khỏe khác.

Các vấn đề sức khỏe có thể phát sinh khi Aspergillus niger phát triển trong môi trường phù hợp và gây ra nhiễm trùng, đặc biệt là ở đường hô hấp. Các triệu chứng của nhiễm trùng nấm có thể bao gồm ho, khó thở, đau ngực và sốt. Các bệnh nhân có hệ miễn dịch suy giảm, như những người nhiễm HIV/AIDS hoặc những người đang trong quá trình hồi phục sau phẫu thuật ghép tạng, có nguy cơ cao hơn để phát triển các biến chứng nghiêm trọng từ nhiễm trùng nấm.
Ngoài ra, Aspergillus niger cũng có khả năng sản xuất các chất độc hại, như mycotoxins, trong môi trường phù hợp. Mycotoxins có thể gây ra các vấn đề sức khỏe nếu tiêu thụ qua thực phẩm hoặc hít phải trong không khí.
Một số bệnh lý do Aspergillus niger gây ra
Aspergillus niger có thể gây ra một số bệnh lý khi nó xâm nhập vào cơ thể và gây nhiễm trùng, đặc biệt là ở những người có hệ miễn dịch suy giảm. Dưới đây là một số bệnh lý do Aspergillus niger gây ra:
- Viêm phổi nấm (Aspergillosis): Aspergillus niger có thể gây ra viêm phổi nấm, một bệnh lý nghiêm trọng đặc biệt phổ biến ở những người có hệ miễn dịch yếu. Triệu chứng có thể bao gồm ho khan, khó thở, sốt, và đau ngực. Viêm phổi nấm có thể trở nên nghiêm trọng và gây ra các vấn đề sức khỏe nghiêm trọng hơn nếu không được điều trị kịp thời.
- Nhiễm trùng huyết (Bacteremia): Trong một số trường hợp, Aspergillus niger có thể gây ra nhiễm trùng huyết, khi nấm xâm nhập vào hệ tuần hoàn của cơ thể thông qua máu. Đây là một tình trạng nghiêm trọng và có thể gây ra biến chứng nguy hiểm.
- Nhiễm trùng đường tiêu hóa: Aspergillus niger cũng có thể gây ra nhiễm trùng đường tiêu hóa, đặc biệt là ở những người tiêu dùng thuốc kháng sinh hoặc corticosteroid trong thời gian dài, làm suy giảm hệ thống miễn dịch của cơ thể.
- Nhiễm trùng vết thương: Trong một số trường hợp, Aspergillus niger có thể gây ra nhiễm trùng trong vết thương hoặc sau phẫu thuật.
- Nhiễm trùng tai biến sau phẫu thuật: Trong môi trường phẫu thuật, Aspergillus niger cũng có thể gây ra các biến chứng nhiễm trùng sau phẫu thuật, đặc biệt là ở những bệnh nhân có hệ miễn dịch suy giảm.

Một số phương pháp điều trị bệnh do nấm mốc Aspergillus niger gây ra
Việc điều trị bệnh do nấm mốc Aspergillus niger gây ra thường phụ thuộc vào mức độ nghiêm trọng của bệnh và tình trạng sức khỏe của bệnh nhân. Dưới đây là một số phương pháp điều trị phổ biến:
- Thuốc chống nấm (Antifungal drugs): Thuốc chống nấm được sử dụng để điều trị các loại bệnh nấm, bao gồm cả Aspergillosis. Các loại thuốc như Amphotericin B, Itraconazole, Voriconazole và Posaconazole thường được sử dụng. Sự lựa chọn của thuốc sẽ phụ thuộc vào loại bệnh, tình trạng sức khỏe của bệnh nhân và độ nhạy cảm của nấm với các loại thuốc này.
- Phẫu thuật: Trong một số trường hợp nghiêm trọng, đặc biệt là khi nấm đã tạo ra các tế bào nang (cysts) hoặc vết áp xe, phẫu thuật có thể được thực hiện để loại bỏ các mô nhiễm nấm.
- Chăm sóc hỗ trợ: Nếu bệnh nhân bị suy giảm miễn dịch, việc cung cấp chăm sóc hỗ trợ như dùng corticosteroids để giảm viêm, cung cấp oxy, hoặc hỗ trợ thở có thể được áp dụng.
- Điều trị các biến chứng: Nếu nấm Aspergillus niger đã gây ra các biến chứng như viêm phổi, việc điều trị các triệu chứng và biến chứng cụ thể của bệnh như ho, khó thở, và sốt là rất quan trọng.
- Tránh tiếp xúc tiếp xúc với nấm: Đối với những người có nguy cơ cao nhiễm trùng nấm, tránh tiếp xúc với môi trường mà nấm có thể phát triển là quan trọng. Điều này có thể bao gồm sử dụng khẩu trang và bảo vệ mắt khi làm việc trong môi trường có nấm, đặc biệt là trong các cơ sở y tế.

Việc chẩn đoán chính xác và điều trị kịp thời là rất quan trọng để ngăn chặn sự phát triển và lây lan của bệnh nấm Aspergillus niger và giúp bệnh nhân phục hồi nhanh chóng và an toàn.
Bài viết trên đã cho chúng ta thêm thông tin về nấm mốc Aspergillus niger. Việc nhận biết và điều trị kịp thời các bệnh lý liên quan đến Aspergillus niger là rất quan trọng, đặc biệt là đối với những người có hệ miễn dịch suy giảm. Đồng thời, việc duy trì môi trường sạch sẽ và hạn chế tiếp xúc với nấm trong các môi trường có nguy cơ cũng là biện pháp phòng ngừa quan trọng.
:format(webp)/Option_1_2_2d9677e5fd.png)
:format(webp)/Option_1_1_2a84e0cd00.png)
:format(webp)/tran_huynh_minh_nhat_905ca436dd.png)